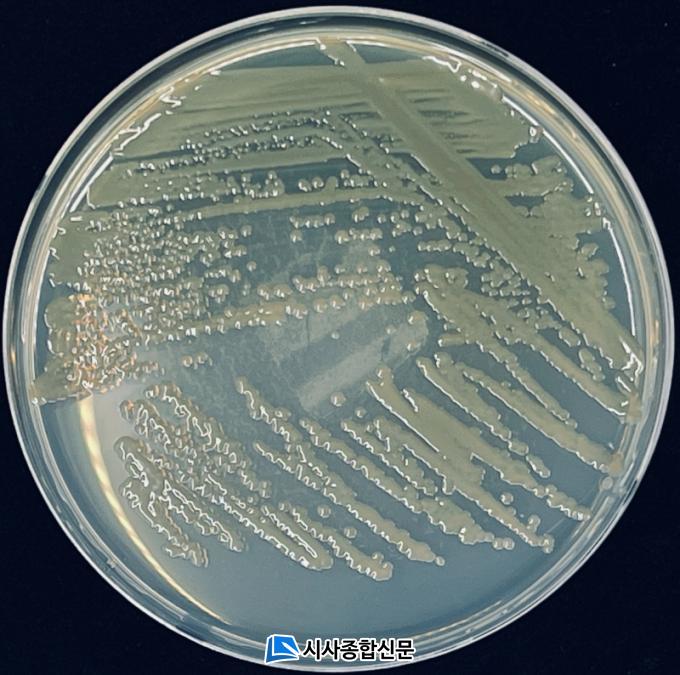

염생식물은 갯벌의 대표적인 탄소고정 생물로 유기물 정화와 연안 침식 방지에 중요한 역할을 할 뿐 아니라 식용‧약용, 관광자원 등 다양한 분야에 활용되고 있으며, 미생물 역시 식물의 호르몬 합성, 환경 스트레스 대응 및 병원균 저항 등 식물 생장에 긍정적인 영향을 미치는 것으로 알려져 있다.
그에 반해 ‘염생식물에 공생’하는 미생물의 다양성과 기능에 관한 연구는 아직 미흡하여 국립호남권생물자원관에서는 그 공백을 보완하고자 이번 연구를 추진했다고 밝혔다.
그 중 항생물질을 생합성하는 두 균주*의 유전체 정보를 한국미생물학회지(Korean Journal of Microbiology) 12월호를 통해 공개하였고 유전학적 후속 연구를 통한 성과도 국내·외 전문학술지 등에 순차 보고할 예정이다.
김창균 국립호남권생물자원관 도서생물자원연구실장은 “갯벌의 주요한 탄소저장고 중 하나로 주목받는 염생식물에 공생하며 생장 촉진에 관여하는 세균의 발굴은 향후 미생물을 활용한 갯벌 보존, 유용 생물소재 개발 등 생물자원 활용 연구를 위한 초석이 될 것”이라고 밝혔다.


 2026.04.06 (월) 14:59
2026.04.06 (월) 14:59